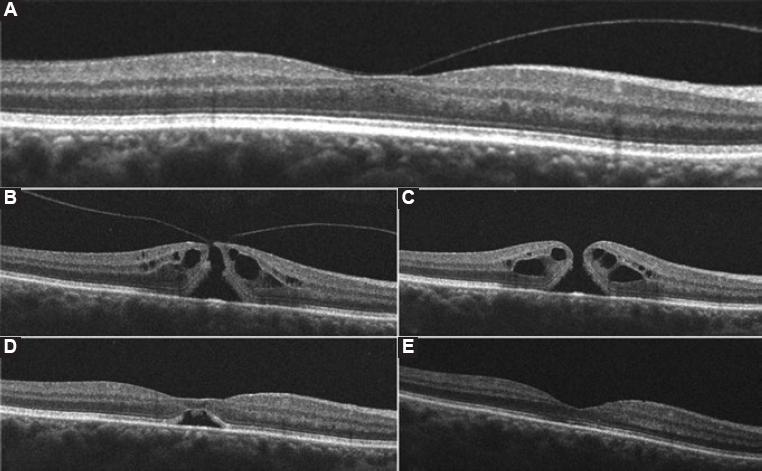

Background
Idiopathic macular holes (IMH) are around full-thickness discontinuity of the foveal neurosensory retina and represent a common macular disease that affects central vision1. According to the clinical classification of Gass, IMH's can be divided into four stages; Stage 1 being impending macular holes and Stages 2-4 full-thickness macular holes2,3. As supported by current Level I evidence, pars plana vitrectomy (PPV) with or without internal limiting membrane peeling and gas endotamponade is considered the treatment of choice for Stage 2-4 macular holes4,5. Despite its excellent success rate, adverse consequences as the acceleration of nuclear sclerosis6, retinal pigment epithelium alterations, retinal detachment (RD), persistence and reopening of the hole, cystoid macular edema, visual field defects, choroidal neovascularization, and endophthalmitis cannot be ignored7-9. The intravitreal injection of inert expansile gas is a safer, minimally invasive alternative to PPV. The success rate depends on the stage of the IMH and their individual presentation8,10. We report the case of an IMH Stage 2 successfully treated with an intravitreal injection of perfluoropropane (C3F8) at a previously unreported dose as initial therapy.
Clinical case
A 61-year-old woman with a previous history of hypothyroidism, cataract surgery on both eyes (OU) and broad vitreomacular traction (VMT) on the right eye (OD) (Fig. 1A), presented to the retina and vitreous clinic with a 10-day history of sudden-onset metamorphopsia and blurred vision OD. Best-corrected visual acuity (BCVA) was 20/125 OD and 20/20 on the left eye (OS). Anterior segment biomicroscopy revealed no alterations OU. Posterior segment examination by means of indirect ophthalmoscopy of OD showed around xanthophyllic circle with evidence of a small retinal defect in the center of the macula and a partial perifoveal posterior vitreous detachment (PVD) consistent with a Stage 2 IMH according to Gass' classification. Diagnosis confirmation with macular optical coherence tomography (OCT) demonstrated a primary small macular hole with VMT in agreement with the International Vitreomacular Traction Study classification system for macular hole11 (Fig. 1B). The rest of the posterior segment examination was unremarkable OU.
Figure 1 Horizontal high-definition optical coherence tomography images of the right macula and their correspondent best-corrected visual acuity (BCVA) at the time. A: Imaging before the onset of visual symptoms shows a split of the vitreous cortex with broad vitreomacular traction (VMT) and a resultant partial loss of foveal depression with intraretinal fluid (BCVA 20/20). B: Imaging after the onset of visual symptoms reveal perifoveal vitreous detachment, focal VMT along with a full-thickness hourglass shape defect of the neurosensory retina, surrounded by a cuff of intraretinal cysts; hole aperture size was 226µm and maximal foveal thickness was 433µm (BCVA 20/125). C: One week after gas injection a complete posterior vitreous detachment, rounding off the edges of the retinal defect and a slight increase in the cuff-like thickened zone of intraretinal cysts can be seen. Maximal foveal thickness was 450 µm (BCVA 20/100), D: 2 weeks after perfluoropropane injection an anatomic closure of the retinal defect with the partial morphological recovery of the foveal depression and a remaining subfoveolar neurosensory retinal detachment are demonstrated (BCVA 20/100), E: 4 weeks postoperatively, a full morphologic and functional recovery is shown with full anatomic integrity of inner and outer retinal layers (BCVA 20/20).
Intravitreal injection through pars plana of 0.2 ml of 100% C3F8 gas was offered to our patient and performed in an operating room using the sterile technique, topical anesthesia, povidone-iodine, topical antibiotics, eyelid speculum, and a 27-gauge needle with a 3-ml syringe. Uncorrected visual acuity was verified to be at least of count fingers and arterial pulse of the central retinal artery confirmed to be present by means of indirect biomicroscopy. Broad-spectrum antibiotic eye drops 4 times a day for 4 days, and posture measures were prescribed: 1 week in sitting position (to achieve PVD) and 1 week in reading position (to achieve anatomic closure). Intraocular pressure was normal on the 1st post-operative day.
One week after the procedure, a macular OCT evidenced PVD and resolution of VMT with a subsequent increase in the maximal foveal thickness, intraretinal cysts and a decrease of the hole aperture size (Fig. 1C). By week 2 postoperatively, OCT evidenced anatomic closure, with a remaining subfoveolar neurosensory RD (Fig. 1D); and a BCVA of 20/100. Regular follow-up demonstrated progressive morphologic improvement with full neurosensory reattachment, restoration of normal foveal contour and preservation of cytoarchitecture of the inner and outer retinal layers with a BCVA of 20/20 OU 4 weeks postoperatively (Fig. 1E). After a 6-month follow-up, morphologic and functional stability were maintained. No adverse events due to the intravitreal injection of C3F8 were presented.
Discussion
Intravitreal injection of 0.2 ml of C3F8 proved to be effective in producing PVD, the release of VMT and anatomic closure of Stage 2 IMH with long-term stability. Gass hypothesized that IMH's begin with tangential traction of the perifoveal vitreous cortex that results in foveal dehiscence and progress from foveolar detachment to full-thickness IMH2,3. The serial high-definition OCT images obtained in our patient support the current theory that the course of the condition begins with perifoveal PVD and is continued by anteroposterior and dynamic VMT12,13. The prevalence of IMH's has been estimated in 0.1-0.8% of adults aged >40 years with an age-adjusted incidence of 7.8/100,000 of the general population per year13. Two-thirds of patients are females and unilateral involvement is seen in about 80% of the cases14.
The intravitreal injection of 0.2 ml of C3F8 as initial therapy for a case of macular hole presenting with BCVA of 20/125, VMT, hole aperture size of 226 µm and maximal foveal thickness of 433 µm has not been described yet. The occurrence of complete PVD 1 week after gas injection in our patient is consistent with previous reports8,10. A pilot study made by Chan et al.10 first demonstrated that the intravitreal injection of 0.3-0.5 ml of C3F8 could produce PVD with release of VMT in 95% of eyes with IMH Stages 1-3 and that a closure rate of 91% of Stage 1, and 50% of the Stage 2 IMH's could be achieved. A more recent study with a larger sample, made by Mori et al.8 reported a rate of PVD and IMH Stage 2 closure of 95% and 50%, respectively. Sulfur hexafluoride (SF6) was used in this study, arguing a lower rate of the retinal hole, tear, or detachment due to its shorter intravitreal half-life8. It was demonstrated that IMH's with aperture sizes <200 and BCVA better than 20/40 achieved anatomic closure more frequently than larger holes8.
After PVD and VMT release, we observed in our patient a more even distribution of intraretinal fluid which may have elicited an increase in maximal foveal thickness, a consequent rounding of the hole edges, and a decrease of the hole aperture size (Fig. 1C). Two weeks after this sequence of events, anatomic closure with reabsorption of intraretinal fluid and a small neurosensory detachment were evident (Fig. 1D). Complete neurosensory reattachment occurred 2 weeks later (Fig. 1E). Intravitreal C3F8 at a dose of 0.2 ml proved to be safe. Significant ocular hypertension after gas injection was absent and, therefore, a paracentesis was not needed. Because the anatomical closure took place in a period of 14 days after the procedure, a shorter intravitreal half-life gas such as SF6 could be used initially; nevertheless, a longer lasting bubble such as that of C3F8 could enhance macular stability and provide a better end-result since a subfoveolar neurosensory RD was present in our patient until week 4 after treatment.
Intravitreal injection of an inert expansile gas as the initial treatment of IMHs is a safe alternative, with minimal morbidity, few adverse events, less discomfort, and potentially great long-term anatomic and functional results. We suggest the use of 0.2 ml of C3F8 for the treatment of primary IMHs Stage 2 with hole aperture size <250 µm, regardless of maximal foveal thickness, and even in cases with a presenting BCVA worse than 20/40 as a less invasive and alternative initial therapy. Studies with larger samples are required to enrich current evidence, identify the best-suited cases for intravitreal gas injection as well as the type and dose of the inert gas to be used.











 nueva página del texto (beta)
nueva página del texto (beta)


